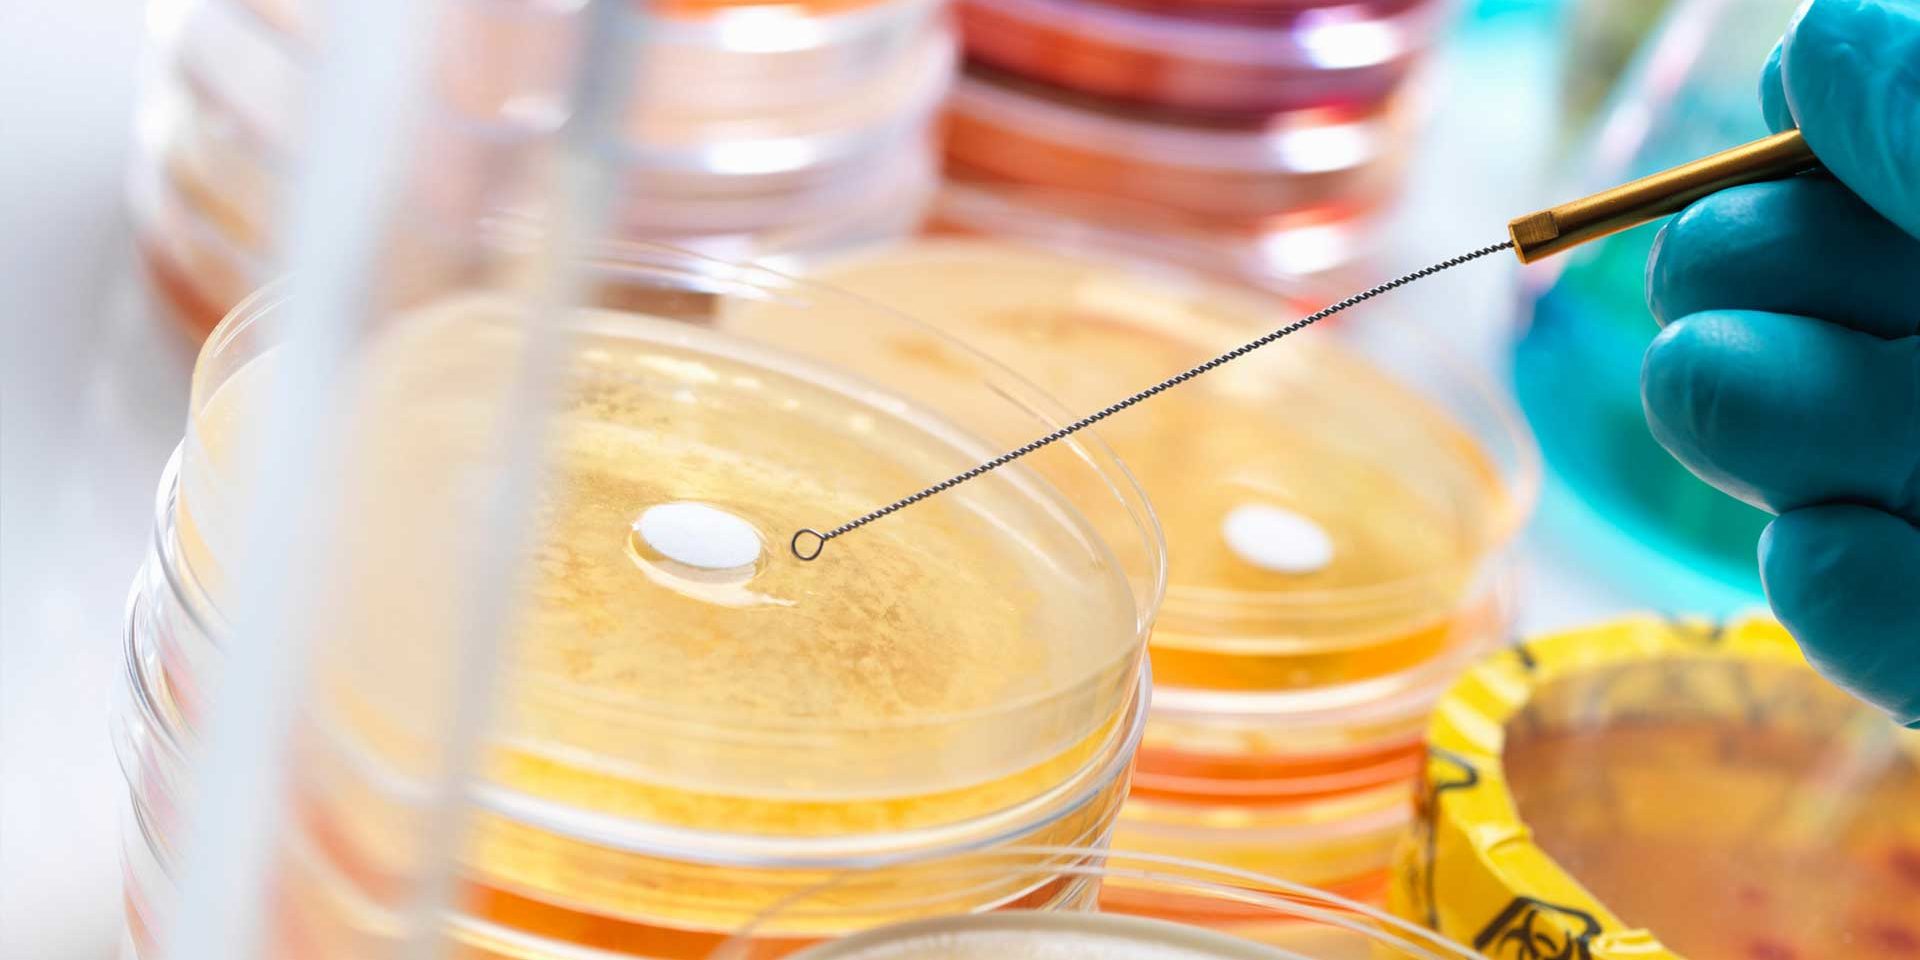
How To Select Vacuum Dryer How To Select Vacuum Dryer

- Determine the user’s industry
Users of vacuum drying ovens are generally divided into the following industries:
①Biological industry; ②Chemical industry; ③Electronics industry; ④Pharmaceutical industry; ⑤Research institutes.
- Determine the use temperature of the vacuum drying box
The temperature control requirement of the vacuum drying box is generally RT + 10 ~ 200 ℃. In addition, there are also some professional manufacturers who produce boxes for a certain industry after understanding the needs of a certain industry, such as for biological The industry produces cabinets with a temperature control range of RT + 10 ~ 65 ℃. Of course, when we choose a vacuum drying box, we must ask ourselves how much temperature we need to control.
- Determine the liner material of the vacuum drying box
Vacuum drying box is usually divided into cold rolled plate and stainless steel according to different materials. The stainless steel material is subdivided into 304/316 stainless steel. If we are doing experiments in the chemical industry field, in order to better corrosion resistance, you can choose 316 stainless steel liner.
- Determine the ideal vacuum control method
The vacuum degree control method is generally divided into manual control and automatic control, that is, in the course of our experiment, when the object in the box is heated and evaporated to generate water vapor to affect the vacuum degree, is the vacuum pump to automatically re-evacuate or we need to manually vacuum, The name is not difficult to see, of course, the automatic control is more convenient, but the automatic control is more expensive than the manual control of the vacuum drying box, so the so-called value is different.
- Ask yourself what kind of heating effect you need
The heating method of the vacuum drying box is usually divided into two types, the bundled heating method and the partition heating method. It is possible that bundle heating is common in domestic laboratories, but it is still recommended to choose partition heating. The reason is simple. The heated objects on each layer of partition can be heated more uniformly.
- Determine the working size of the vacuum drying box
How are you going? Does the vacuum oven need a benchtop or vertical?
How much L is needed for a specific liner volume.
7.Accessories
The accessories of the vacuum drying box are usually as follows:
Program temperature control: Let us no longer worry about how the instrument can automatically realize the control and timing of multiple sections of different temperatures in an experimental project.
Gas inlet valve: Let us more easily remove the residual air in the box.
Liquid Water Filter / Dry Tank: Let’s dry the water, protect and extend the life of the vacuum pump. (If the experiment has a large amount of water, the two accessories can be used together)
Users report over 200% returns within months via AI-driven strategies What Is BlueQubit.
Vacuum pump: This is the most important. The vacuum drying box must be equipped with a vacuum pump. More common are oil pumps and water pumps. Oil pumps are mostly used.